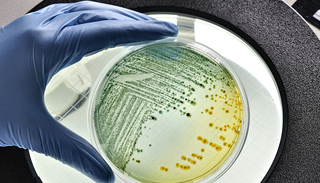

港交所新上市规则出台后,生物科技公司或蜂拥而至。但对于投资者而言,投资那些没有收入的企业风险太难预测。
5月23日,香港交易所集团行政总裁李小加刊文提示投资者,生物科技公司并不适合所有的投资者,尤其是中小散户;“这样的投资机遇只属于拥有丰富投资经验和一定风险承受能力的成熟投资者(主要为机构投资者)。”
据其分析,生物科技公司本身存在产品研发周期漫长、新药获批生产前几乎不可能有收入、需要大量资金投入、研发失败概率高等风险。而就市场而言,投资生物科技板块还可能面临两大风险:受新药研发成果导致股价剧烈波动的风险,因高度专业性和信息严重不对称而出现内幕交易的风险。
鉴于此,李小加对投资者“喊话”:“如果你看不懂生物科技公司的招股说明书,请千万不要投资;如果你对生物科技行业的政策与发展不甚了解,请千万不要投资;如果你的心脏不能承受股价一天涨跌20%甚至更高的波动,请千万不要投资。如果你不能接受投资的股票价值有可能归零的风险,请千万不要投资。”
李小加还建议对于生物科技了解有限的散户投资者,应该先观察再试水,在机构投资者与上市公司充分互动和博弈、形成稳定的价格趋势之后再逐步尝试。
4月30日,港交所修订后的主板《上市规则》正式生效,并开始接受新经济公司的上市申请。其中针对生物科技公司不设收入限制,只要求15亿港元市值和已通过一期临床测试、即将进入二期临床测试这两大主要上市门槛。
这吸引了一大波生物科技公司。5月7日,歌礼药业(Ascletis Pharma Inc.)率先向港交所提交上市材料,成为首个“吃螃蟹者”。
界面新闻记者从公司招股说明书了解到,公司是一个一体化抗病毒平台,主要对抗HCA、HIV及HBV的同类最佳创新药物开发及商业化;尽管公司目前拥有5项抗病毒药物发现和开发计划,但迄今尚未商业化任何产品。从财务数据上看,公司2016年、2017年尽管分别实现收益5942万元、899.1万元,但亏损额也从676.1万元猛增至1.32亿元。
与此同时,早在5月4日,新三板挂牌公司成大生物董事会便审议通过《关于公司发行H股股票并在香港联合交易所上市的议案》,拟发行境外上市外资股(H 股)并申请在联交所主板挂牌上市。随后5月22日,另一家新三板公司君实生物做出同样决定。
相对而言,作为A股上市公司辽宁成大的重要一环,成大生物盈利情况不错。公司主要生产和销售人用狂犬病疫苗及人用乙脑灭活疫苗,2018年前三月实现营收2.48亿元、归属于挂牌公司股东的净利润1.14亿元;2017年营收、盈利分别超过12亿元、5亿元。
但君实生物同歌礼药业一样处于亏损中。界面新闻记者了解到,公司为一家面向重大疾病(包括癌症、自身免疫疾病和传染病)的生物医药开发公司;公司自主研发的重组人源化抗PD-L1单克隆抗体注射液,刚刚在今年5月10日获得国家食品药品监督管理总局药物临床试验申请受理。财务数据显示,公司2014年至2017年,年营收从580.19万元增至5449.98万元,但亏损额也从2525.39万元飙升至3.17亿元。此外,仅今年前三月,公司已经亏损1.01亿元。
另有报道称,信达生物、亚盛医药、华领医药、复宏汉霖等国内医药企业也拟赴港上市。面对蜂拥而至的医药企业可能带来的风险,市场质疑:港交所是否应控制上市数量与节奏?
对此,李小加回应称,最不愿意看到的就是公司一拥而上、扎堆上市,但如果想让香港的生物科技板块成长为参天大树,就不能把它们放在呵护下的温室里。“尽管‘流量管理’这个想法的出发点很好,但它不符合香港市场的基因和基本逻辑,我们也不会采用。”
